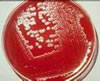

| İnfeksiyon |

İnfeksiyon |
| Canlı kapması,canlı girmesi. Bakteri, virüs, fungus ya da protozoonların bir organizmaya girmesi. Enfeksiyon yapan organizmaların bir hücre ya da canlıda meydana getirdiği durum. |
| İnfeksiyon |
İnfeksiyon |
| Canlı kapması,canlı girmesi. Bakteri, virüs, fungus ya da protozoonların bir organizmaya girmesi. Enfeksiyon yapan organizmaların bir hücre ya da canlıda meydana getirdiği durum. |